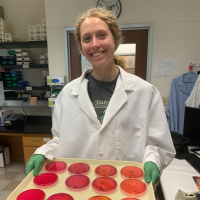

The Fellowship Excellence Award goes to one USDA Wallace-Carver Fellow each year in recognition of fellow’s accomplishments and performance. The award include a $1,000 prize.
2024 Fellowship Excellence Award RecipientEllen Schloemer
Ellen Schloemer of St. Marys, Ohio, and student at The Ohio State University received the 2024 Fellowship Excellence Award. Ellen received the Fellowship Excellence Award for her outstanding scientific poster, personal and professional growth during her fellowship, commitment to the experience and outstanding ambassador of the Foundation during her USDA... [ View ] |


